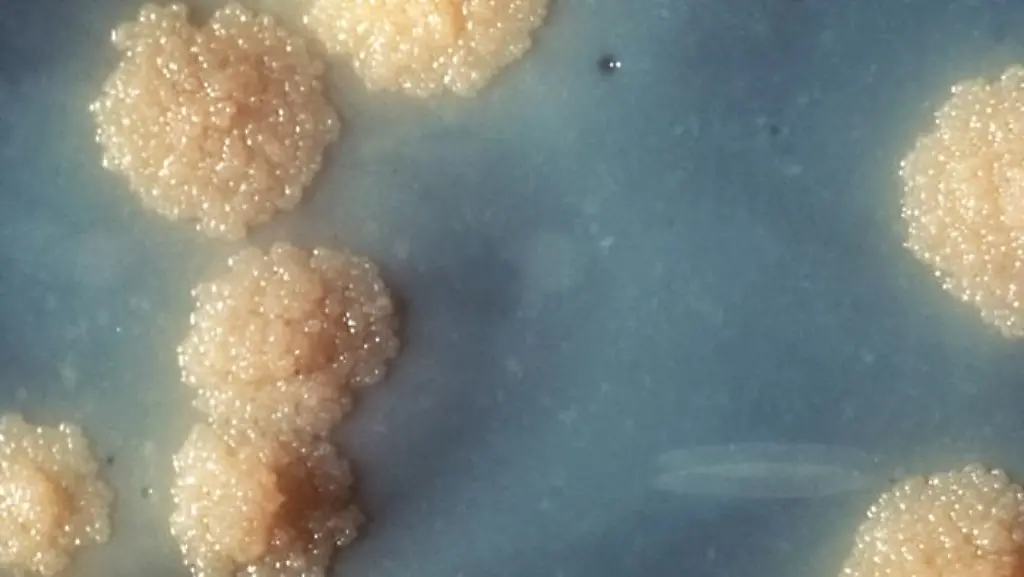
TBC

Beunruhigende Entwicklung in DeutschlandTuberkulose bleibt bedrohlich
Besiegt war der gefährliche Tuberkel-Erreger noch nicht, aber er ließ sich in Schach halten. Die Zahl der Tuberkulose-Fälle in Deutschland ging stark und stetig zurück - bis vor wenigen Jahren. Nun mahnen Mediziner zu "besonderer Wachsamkeit".
1907, ein Sanatorium in Davos: Tuberkulose beherrscht den Alltag. Die ansteckende Krankheit gibt den Tagesablauf der Patienten vor. Sie bestimmt ihre Gedanken und ihre Gespräche. Liegekuren an der frischen Luft sollen die Kranken heilen. Davos, auf 1560 Metern in den Schweizer Alpen gelegen, gilt als der einzige Ort, an dem das möglich ist. Doch selbst hier bringt die Tuberkulose, auch Schwindsucht genannt, in viel zu vielen Fällen den Tod.
Die Szenerie ist weltbekannt, sie entstammt einem Roman und gleichzeitig der Realität: Thomas Manns "Zauberberg", erschienen 1924, spielt zu einer Zeit, in der es noch kein wirksames Medikament gegen Tuberkulose gab. Noch galt Tuberkulose als die Krankheit, besonders unter den ärmeren Menschen in einer Stadt. Um 1880 war in Deutschland jeder zweite Todesfall der 15- bis 40-Jährigen auf Tuberkulose zurückzuführen.
Mittel, mit denen die Lungenkrankheit behandelt werden kann, stehen erst seit 1943 zur Verfügung. Mit unterschiedlichen Antibiotika ist es möglich, den Tuberkulose verursachenden Mykobakterien zu Leibe zu rücken. Seitdem die Medikamente im Einsatz sind und sich zudem die allgemeinen Lebensumstände verbesserten, ging die Zahl der Tuberkulose-Fälle in Deutschland stetig zurück - bis 2009. Dann verlor der Trend an Deutlichkeit.
Gefährlichste Infektionskrankheit weltweit
In den vergangenen fünf Jahren nämlich hat sich die Anzahl der hier gemeldeten Tuberkulose-Erkrankungen kaum verringert. Bei Kindern steigen die Zahlen sogar. 2012 verzeichnete das Robert-Koch-Institut (RKI) insgesamt 4220 Fälle. Global betrachtet führt Tuberkulose noch immer die Statistik der tödlichen Infektionskrankheiten an. Mehr als 1,3 Millionen Menschen weltweit sind 2012 daran gestorben; 8,6 Millionen Neuerkrankungen wurden gezählt.
Bislang ist Tuberkulose nicht auszurotten. Eine Impfung erwies sich als unzureichend, in Deutschland wird sie seit 1998 nicht mehr empfohlen. Doch was Mediziner zurzeit wirklich beunruhigt, ist etwas anderes: Immer mehr Tuberkulose-Erreger sind gegen die üblichen Antibiotika resistent. Manche nur gegen eines von diversen möglichen Mitteln, manche aber auch gegen mehrere Mittel gleichzeitig. Bei diesen Erregerstämmen zeigt kaum eine Antibiotika-Therapie noch Wirkung.
Der Anteil von Tuberkulose-Erkrankungen durch die sogenannten multiresistenten Stämme hat in Deutschland in den letzten Jahren zugenommen: 2012 gingen 2,3 Prozent der Fälle auf multiresistente Mykobakterien zurück, zwischen 2009 und 2011 waren es im Mittel noch 1,9 Prozent gewesen. "Die aktuelle Entwicklung bei der resistenten Tuberkulose bedarf einer besonderen Wachsamkeit", warnt das RKI daher in seinem jährlichen Bericht.
Berlin und München über dem Durchschnitt
Wie zu Beginn des 20. Jahrhundert, tritt Tuberkulose auch heute in Deutschland in erster Linie in Großstädten und in Ballungszentren auf. In Berlin oder auch München ist die Zahl der Neuerkrankungen mit 9,3 bis 10 Fällen pro 100.000 Einwohner besonders hoch. Der bundesweite Durchschnitt liegt bei 5,2 Fällen auf 100.000 Einwohner. RKI-Präsident Reinhard Burger fordert daher, die Anstrengungen in der Tuberkulose-Prävention und Früherkennung zu intensivieren.
Tuberkulose wird von Mensch zu Mensch übertragen. Bei der offenen Lungen-TB (78,7 Prozent der in Deutschland registrierten Fälle) gelangt der Erreger durch Husten und Niesen in die Luft. Wer ihn einatmet, kann sich anstecken. Ob das geschieht, hängt zum Beispiel davon ab, wie intensiv der Kontakt zum Erkrankten ist. Die Inkubationszeit beträgt sechs bis acht Wochen.
Doch nicht bei jedem, der sich infiziert, bricht die Krankheit auch aus. Nur etwa 5 bis 10 Prozent der mit dem Mycobacterium tuberculosis infizierten Menschen bekommen im Laufe ihres Lebens tatsächlich Tuberkulose; bei Kindern und Jugendlichen unter 15 Jahren allerdings sind es 20 bis 40 Prozent. In den meisten Fällen bricht die Krankheit nicht aus, weil die körpereigene Abwehr die Erreger eindämmt. Die Weltgesundheitsorganisation (WHO) schätzt, dass ein Drittel der Weltbevölkerung Tuberkuloseerreger in sich trägt.
Starkes Immunsystem hat Erreger im Griff
Möglich ist, dass der Erreger im Organismus schlummert und die Tuberkulose nach Jahren oder gar Jahrzehnten akut wird – dann nämlich, wenn die Abwehrkräfte nachlassen. Das hängt vom Lebensalter und der Abwehrstärke ab. Als besonders gefährdet gelten Kinder im Kontakt mit Erkrankten sowie Menschen mit geschwächtem Immunsystem, so etwa Tumorerkrankte, Diabetiker, HIV-Patienten, Alkohol- und Drogenabhängige. Auch bei Menschen, die auf der Straße leben, kann das Tuberkulose-Risiko erhöht sein, denn häufig sind sie mangelernährt und die hygienischen Umstände sind schlecht.
Bricht die Krankheit aus, befällt Tuberkulose meist die Lunge. Typischerweise äußert sie sich durch Husten und Schmerzen beim Atmen. Wenn sich die Mykobakterien über die Lymph- und Blutbahnen im Körper ausbreiten, können sie allerdings auch andere Organe befallen – etwa Lymphknoten, Nieren oder Harnwege. Patienten mit offener Tuberkulose müssen isoliert werden, solange sie ansteckend sind. Erhalten sie wirksame Medikamente, sind das etwa drei Wochen.
Die Bundeszentrale für gesundheitliche Aufklärung rät, Husten, der länger als drei Wochen anhält, ärztlich beurteilen zu lassen. Denn je rascher eine Tuberkulose erkannt wird, umso schneller kann sie behandelt werden. Die Chancen, dass sie dann folgenlos ausheilt, stehen sehr gut. "Tuberkulose erkennen, verhindern, heilen: alle erreichen" lautet das Motto des diesjährigen Welttuberkulosetages. Mit ihm erinnert die WHO seit 1996 am 24. März daran, dass Tuberkulose nicht Geschichte ist. Im Gegenteil.